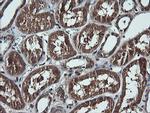
DDX58 Antibody in Immunohistochemistry (Paraffin) (IHC (P))

Search
OriGene
DDX58 Monoclonal Antibody (OTI6C1), TrueMAB™
{{$productOrderCtrl.translations['antibody.pdp.commerceCard.promotion.promotions']}}
{{$productOrderCtrl.translations['antibody.pdp.commerceCard.promotion.viewpromo']}}
{{$productOrderCtrl.translations['antibody.pdp.commerceCard.promotion.promocode']}}: {{promo.promoCode}} {{promo.promoTitle}} {{promo.promoDescription}}. {{$productOrderCtrl.translations['antibody.pdp.commerceCard.promotion.learnmore']}}
产品信息
TA506141
种属反应
宿主/亚型
分类
类型
克隆号
抗原
偶联物
形式
浓度
纯化类型
保存液
内含物
保存条件
运输条件
靶标信息
Retinoic acid-inducible gene I, RIG-I is a pattern recognition receptor (PRR) involved in the recognition of viral dsRNA. Along with MDA5, RIG-I detects viral dsRNA and activates the innate immune response. Both MDA5 and RIG-I are RNA helicases and they perform overlapping as well as distinct roles. RIG-I is activated by dsRNAs without a 5'-triphosphate end and short dsRNAs, whereas MDA5 is activated by long dsRNAs. Once activated, both proteins signal through IPS-1 activating transcription factors NF-kappaB and IRF-3 (1) and ultimately activating apoptosis, cytokine signaling, and inflammation. RIG-I is essential for signaling by influenza A, influenza B, human respiratory syncytial virus (3), paromyxoviruses, Japanese encephalitis virus, and West Nile virus. MicroRNA-146a has been implicated in feedback inhibition of RIG-I-dependant antiviral response by negatively regulating RIG-I targets TRAF6, IRAK1, and IRAK2. Recent evidence has implicated RIG-I in the detection of cytosolic DNA through RNA polymerase III activity.
仅用于科研。不用于诊断过程。未经明确授权不得转售。
篇参考文献 (0)
生物信息学
蛋白别名: Antiviral innate immune response receptor RIG-I; ATP-dependent RNA helicase DDX58; DEAD (Asp-Glu-Ala-Asp) box polypeptide 58; DEAD box protein 58; DEAD/H (Asp-Glu-Ala-Asp/His) box polypeptide; Retinoic acid-inducible gene 1 protein; Retinoic acid-inducible gene I protein; RIG-1; RIG-I; RIG-I-like receptor 1; RLR-1; RNA helicase RIG-I; RNA sensor RIG-I
基因别名: DDX58; RIG-I; RIGI; RLR-1; SGMRT2
UniProt ID: (Human) Q9NT04
Entrez Gene ID: (Human) 23586